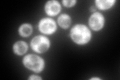
YKL054C
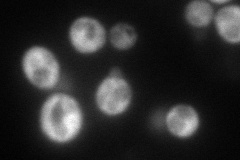
YKL054C
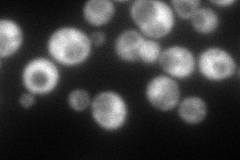
YKL054C
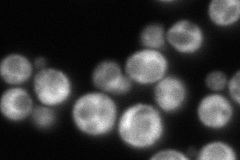
YKL054C
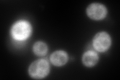
YKL054C
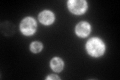
YKL054C

View description
RNAPII degradation factor, forms a complex with Rad26p in chromatin, enables ubiquitination and proteolysis of RNAPII present in an elongation complex; mutant is deficient in Zip1p loading onto chromosomes during meiosis
Localization:
Intensity:
Fold change:
Significance:
-
C’ GFP library in SD
cytosol451.63 -
N' NOP1pr-GFP in SD
cytosol150.417 -
N' TEF2pr-mCherry in SD
cytosol118.517 -
N' NATIVEpr-GFP in SD
cytosol219.015 -
N' TEF2pr-VC and Cyto-VN in SD

#N/A0 -
C’ GFP library in SD+DTT
cytosol599.591.32No -
C’ GFP library in SD+H2O2

cytosol574.361.27No -
C’ GFP library in Starvation Media
cytosol393.720.87No -
C’ GFP library on the background of Pup2-DaMP

cytosol -
C’ GFP library on the background of CCT mutant

cytosol488.2331.08103No
